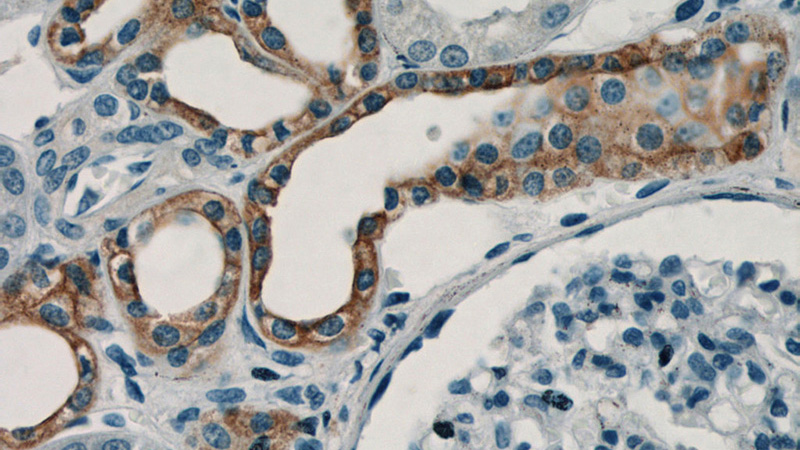
Immunohistochemistry of paraffin-embedded human kidney tissue slide using Catalog No:115179(SH2D1B Antibody) at dilution of 1:50 (under 40x lens)

-
Product Name
SH2D1B antibody
- Documents
-
Description
SH2D1B Rabbit Polyclonal antibody. Positive FC detected in Jurkat cells. Positive IHC detected in human kidney tissue. Positive WB detected in Jurkat cells, HepG2 cells, HL-60 cells, mouse thymus tissue, Raji cells. Observed molecular weight by Western-blot: 15 kDa
-
Tested applications
ELISA, WB, IHC, FC
-
Species reactivity
Human,Mouse,Rat; other species not tested.
-
Alternative names
EAT 2 antibody; EAT2 antibody; SH2 domain containing 1B antibody; SH2D1B antibody
- Immunogen
-
Isotype
Rabbit IgG
-
Preparation
This antibody was obtained by immunization of SH2D1B recombinant protein (Accession Number: NM_053282). Purification method: Antigen affinity purified.
-
Clonality
Polyclonal
-
Formulation
PBS with 0.02% sodium azide and 50% glycerol pH 7.3.
-
Storage instructions
Store at -20℃. DO NOT ALIQUOT
-
Applications
Recommended Dilution:
WB: 1:200-1:2000
IHC: 1:20-1:200
-
Validations

Jurkat cells were subjected to SDS PAGE followed by western blot with Catalog No:115179(SH2D1B antibody) at dilution of 1:800
Immunohistochemistry of paraffin-embedded human kidney tissue slide using Catalog No:115179(SH2D1B Antibody) at dilution of 1:50 (under 40x lens)

1X10^6 Jurkat cells were stained with 0.2ug SH2D1B antibody (Catalog No:115179, red) and control antibody (blue). Fixed with 4% PFA blocked with 3% BSA (30 min). Alexa Fluor 488-congugated AffiniPure Goat Anti-Rabbit IgG(H+L) with dilution 1:1500.
-
Background
SH2D1B, also named as EAT2, an adaptor expressed in innate immune cells, including natural killer (NK) cells. It plays a role in controlling signal transduction through at least four receptors, CD84, SLAMF1, LY9 and CD244, expressed on the surface of professional antigen-presenting cells. EAT-2 overexpression would enhance the innate immune responses and also result in more potent Carcinoembryonic antigen-specific adaptive immune responses.
-
References
- Hagberg N, Theorell J, Schlums H, Eloranta ML, Bryceson YT, Rönnblom L. Systemic lupus erythematosus immune complexes increase the expression of SLAM family members CD319 (CRACC) and CD229 (LY-9) on plasmacytoid dendritic cells and CD319 on CD56(dim) NK cells. Journal of immunology (Baltimore, Md. : 1950). 191(6):2989-98. 2013.
- Schlums H, Cichocki F, Tesi B. Cytomegalovirus infection drives adaptive epigenetic diversification of NK cells with altered signaling and effector function. Immunity. 42(3):443-56. 2015.
- Lee J, Zhang T, Hwang I. Epigenetic modification and antibody-dependent expansion of memory-like NK cells in human cytomegalovirus-infected individuals. Immunity. 42(3):431-42. 2015.
Related Products / Services
Please note: All products are "FOR RESEARCH USE ONLY AND ARE NOT INTENDED FOR DIAGNOSTIC OR THERAPEUTIC USE"
